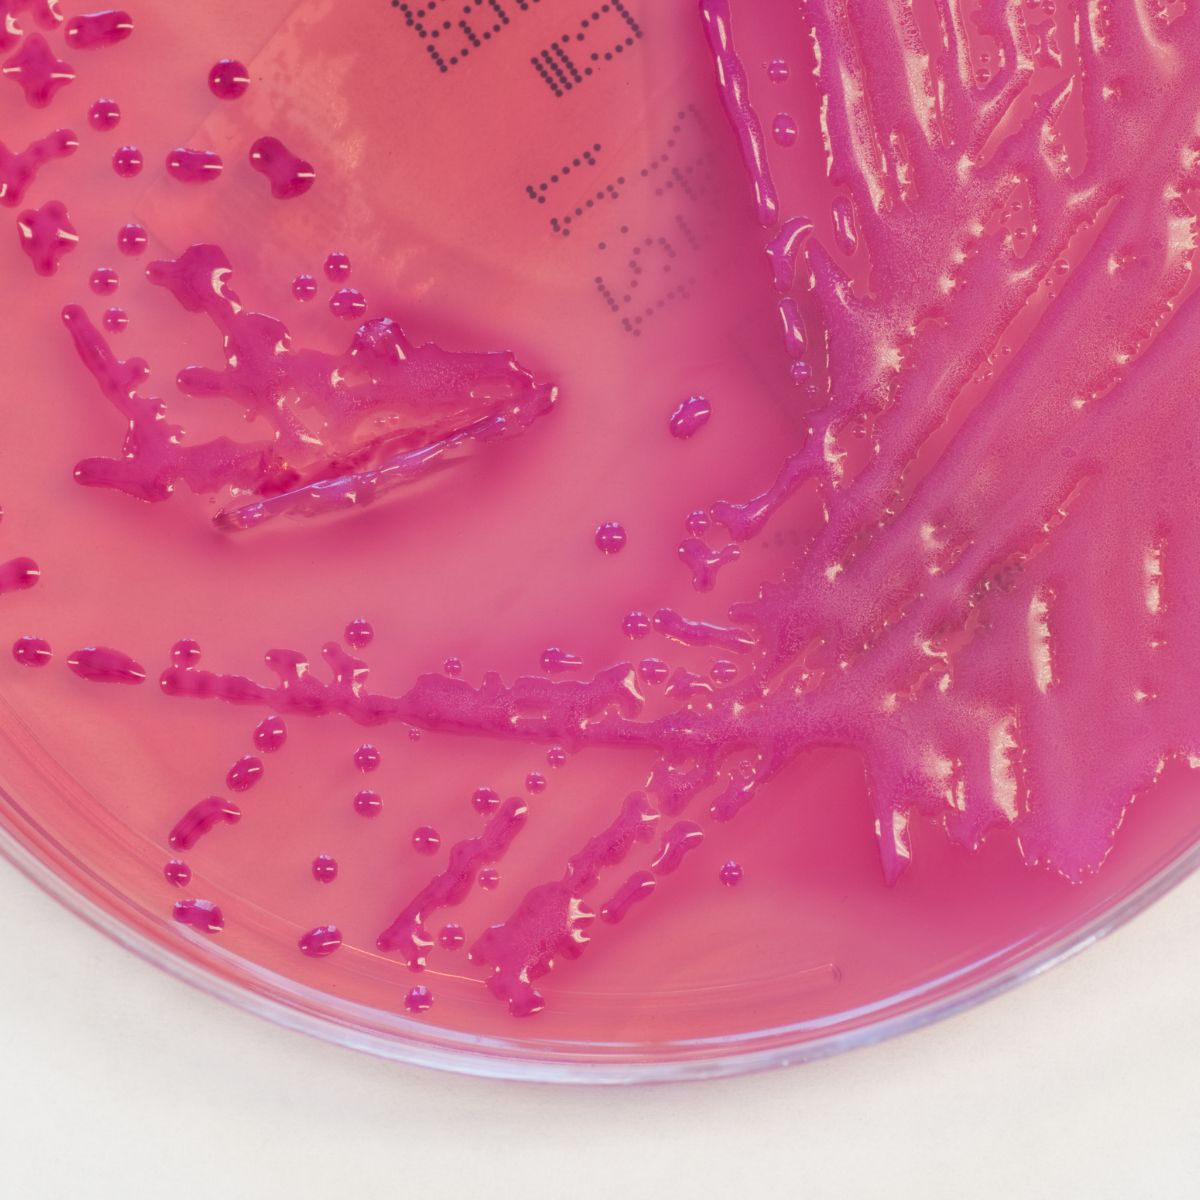

Serviços para saneantes
Ensaios para Saneantes, Superfícies Ativas e Equipamentos de Desinfecção
Avaliação da eficácia microbiológica conforme métodos CEN e AOAC, incluindo testes bactericidas, fungicidas e virucidas. Realizamos ensaios físico-químicos como dosagem de ativos, pH e estabilidade, além de avaliação toxicológica (DL50 teórica) para suporte ao registro e controle de qualidade de formulações saneantes.
Todos os serviços
Resultados rápidos. Delineamento técnico. Garantia da qualidade
Eficácia Microbiológica
Ensaios em suspensão e em carreadores (CEN), testes por diluição de uso (AOAC), eficácia virucida de amplo espectro, inibição específica de vírus, atividade bactericida e fungicida frente a cepas normatizadas, concentração inibitória mínima (MIC), análise de sinergismo entre ativos, definição da diluição de uso ideal.
Avaliação Toxicológica
Cálculo de DL50 teórica para estimativa de toxicidade aguda e suporte ao registro regulatório. Testes toxicológicos para novos ativos.
Eficácia virucida
Estudos de eficácia virucida em BPL reconhecida pelo INMETRO, incluindo testes de amplo espectro e inibição específica de vírus como SARS-CoV-2. Aplicável a produtos hospitalares, veterinários e saneantes com exigência regulatória nacional ou internacional.
Vamos falar sobre seu projeto?
Faça uma reunião conosco sem custo e entenda como podemos ajudar.